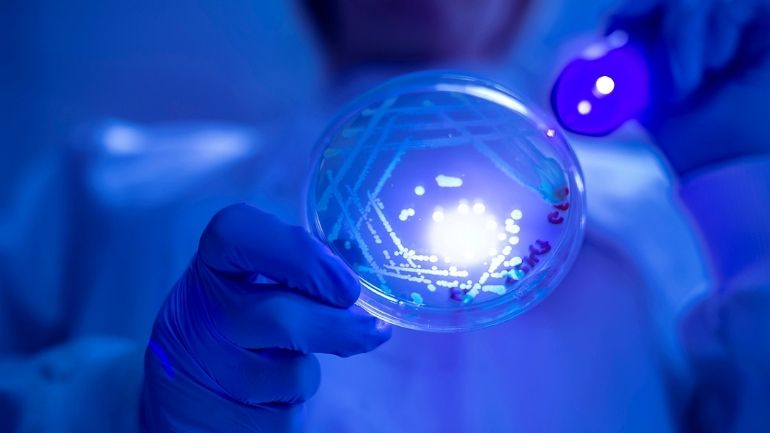
We’re delighted that the University of Leicester has once again been named in the Top 5 UK universities for Clinical Medicine. 👏 #CitizensOfChange

👉 le.ac.uk/news/2021/may/… 👈

researchandenterprisedivision
@researchandent
ID: 1196453598080712707
18-11-2019 15:42:27
271 Tweet
68 Takipçi
116 Takip Edilen




So much thanks to Dr Elpida Vounzoulaki who kept us going with her 5 minute Lunchtime Lecture recently as we aren't allowed to be at the Adult Education Centre who are doing tremendous work as a COVID testing venue currently #CitizensOfChange #TheDoctoralCollege





Professor Sue Page from Leicester Geography addressed @ClimateExp0 last week, putting forward the case for better management of peatlands to fight climate change. #CitizensOfChange 👉 le.ac.uk/news/2021/may/… 👈


Congratulations to @DrAngelaMuir of History at Leicester for winning the Francis Jones Prize for Welsh History!


Delighted to be part of the amazing team of people recognised with the 2021 Dalton Division Horizon Prize! MillsGroup Dr Conrad Goodwin Prof. Nicholas F Chilton #RSCPrize UoM Chemistry Leicester Chemistry rsc.org/prizes-funding…






The countdown is over Space Park Leicester opened its doors today as part of the transition to full occupancy. It promises to be a fantastic working environment for business, researchers, students, KE professionals and support staff.